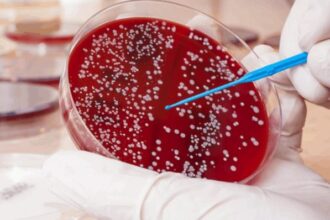

Báo Alo Úc
Khám phá nước Úc qua những hình ảnh và video
Úc là một quốc gia thân thiện, an toàn và đầy cơ hội, thường được xếp hạng cao trong các chỉ số hạnh phúc toàn cầu. Nếu bạn muốn biết thêm về một khía cạnh cụ thể như du lịch, ẩm thực (thử vegemite hoặc thịt nướng BBQ!) hay lịch sử, hãy hỏi tôi nhé